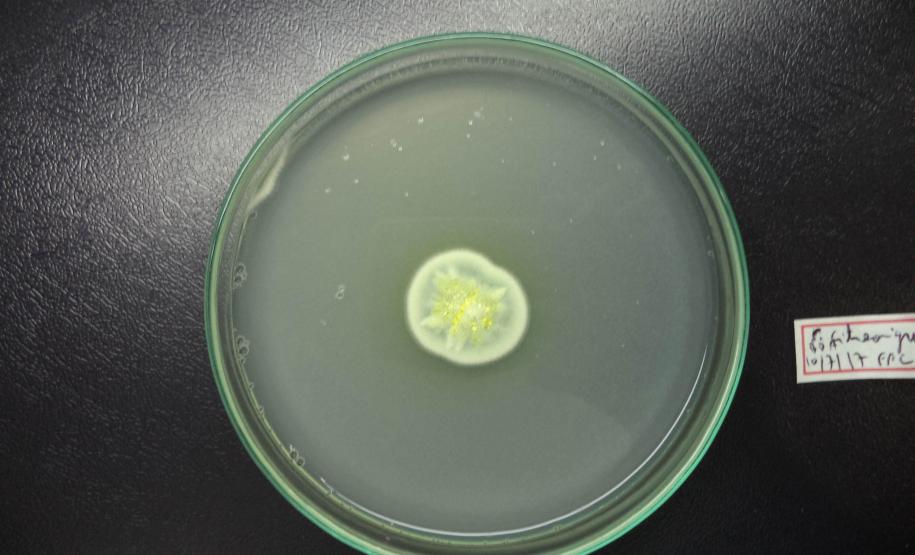
Revista científica do Tecpar amplia visibilidade de pesquisadores paranaenses

Revista científica do Tecpar amplia visibilidade de pesquisadores paranaenses 01/06/2023 - 12:30
A revista científica Brazilian Archives of Biology and Technology (BABT), editada pelo Instituto de Tecnologia do Paraná (Tecpar), registrou um aumento na participação de pesquisadores paranaenses com artigos publicados no periódico. De janeiro a maio de 2023, só o Paraná contribuiu com 20,5% da produção científica divulgada na revista, que tem alcance internacional. Os demais trabalhos são de autores internacionais (48%) e de outros estados do Brasil (32%).
Dos 88 artigos publicados neste período, 18 contam com autores de universidades estaduais e federais do Paraná, além de um trabalho desenvolvido pela Pontifícia Universidade Católica do Paraná (PUC-PR), em parceria com o Tecpar. O número equivale ao total de artigos com autores paranaenses durante todo o ano de 2022.
A maioria dos artigos publicados em 2023 é do segmento de biologia e ciências aplicadas (22). Em segundo lugar, com 17 publicações cada, aparecem os trabalhos sobre saúde humana e animal; agricultura, agronegócio e biotecnologia; e engenharia e tecnologias. Também foram publicados nove artigos sobre tecnologia dos alimentos e seis da área de ciências ambientais.
O periódico BABT iniciou suas atividades em 1946 e desde então divulga artigos originais de pesquisa e revisões, contribuindo para o avanço da ciência, tecnologia e inovação. Desde 2001, a revista está disponível em formato eletrônico na SciELO, biblioteca digital de artigos científicos com acesso aberto. Em 2022, para celebrar o marco de 75 anos do BABT, o Tecpar lançou a edição impressa comemorativa com artigos de pesquisadores paranaenses. A publicação contém 32 trabalhos escritos por 174 autores de 30 instituições do Paraná.
De acordo com o diretor-presidente do Tecpar, Celso Kloss, a revista representa, de forma consistente, a contribuição do Tecpar para o fortalecimento e crescimento da produção científica no Paraná e no Brasil. "A revista vem consolidando sua posição como uma forte ferramenta para que os pesquisadores paranaenses publiquem suas pesquisas, em um instrumento ágil e reconhecido no contexto da produção do conhecimento científico", salientou.
A gerente do Centro de Informações Tecnológicas do Tecpar, Lívia Nogueira dos Santos, destaca que a credibilidade do periódico BABT tem crescido graças ao esforço da equipe editorial em implantar melhorias – da seleção à publicação de artigos de alto nível. Segundo ela, além de ser referência na produção do conhecimento científico, o instituto busca incentivar e valorizar o trabalho dos pesquisadores paranaenses.
“Temos observado que a qualidade dos trabalhos publicados na revista tem crescido a cada ano, fazendo com que os artigos sejam cada vez mais citados. Esse reconhecimento nacional e internacional faz com que os pesquisadores locais também se interessem em divulgar seus trabalhos nesta publicação que é 100% paranaense”, ressalta.
AUTORES PARANAENSES – Um dos artigos publicados recentemente no BABT contou com a participação de quatro pesquisadores da Universidade Estadual de Maringá (UEM). O trabalho foi desenvolvido pelos professores Sérgio Paulo Severo de Souza Diniz, Ione Parra Barbosa-Tessmann, Fausto Fernandes de Castro e José Roberto Dias Pereira, com a participação dos pesquisadores Roberto Messias Bezerra, da Universidade Federal do Amapá, e Isamu Kanzaki, da Universidade de Brasília.
A professora Ione, que é Ph.D. em Bioquímica e Biologia Molecular, explica que os pesquisadores isolaram um fungo chamado Penicillium citreosulfuratum, presente em partes metálicas corroídas de peças da Usina Hidrelétrica Coaracy Nunes (AP). Este fungo, que cresce na presença de uma grande quantidade de alumínio, foi identificado por meio de técnicas de biologia molecular.
Em seguida, os pesquisadores realizaram testes com óleos essenciais de tomilho, orégano, melaleuca e menta, para saber como o fungo poderia ser controlado.
“Nós vimos que alguns óleos atuavam bem no controle do crescimento desse fungo. Você pode trabalhar com óleos essenciais nas partes metálicas de hidroelétricas, prevenindo o crescimento desse fungo, o que poderia prevenir a biocorrosão. Além disso, como esse fungo sobrevive em uma grande quantidade de alumínio, é possível que ele capte este metal do meio e possa ser usado como um bioremediador em locais muito contaminados com alumínio, por exemplo”, explica Ione.
Em conclusão, os resultados mostram que o fungo pode formar um biofilme em fios de alumínio, cresce na presença de altas concentrações de alumínio e zinco e os óleos essenciais de tomilho e orégano podem controlar bem o seu crescimento. A pesquisa foi publicada na edição mais recente do BABT, que pode ser acessada AQUI.
“Tive interesse em publicar no BABT porque é uma revista que cresceu bastante nos últimos anos e está com fator de impacto bom. Eu fiquei muito feliz porque vi uma melhora no nível da revista como um todo. É uma revista paranaense de impacto, que é muito bem cuidada pelos editores”, afirma a pesquisadora.
OUTROS PAÍSES – Ao mesmo tempo em que amplia a visibilidade dos autores paranaenses, o BABT tem avançado na internacionalização: quase a metade das publicações científicas de 2023 foram enviadas por autores internacionais, um total de 43 artigos.
No Brasil, o BABT é apoiado por importantes instituições ligadas à produção científica, como o CNPq, Conselho Nacional de Desenvolvimento Científico e Tecnológico; a Capes, Coordenação de Aperfeiçoamento de Pessoal de Nível Superior; o Programa de Apoio a Publicações Científicas do Ministério da Ciência e Tecnologia; Ministério da Educação; a Superintendência Geral de Ciência, Tecnologia e Ensino Superior do Paraná; e a Fundação Araucária.